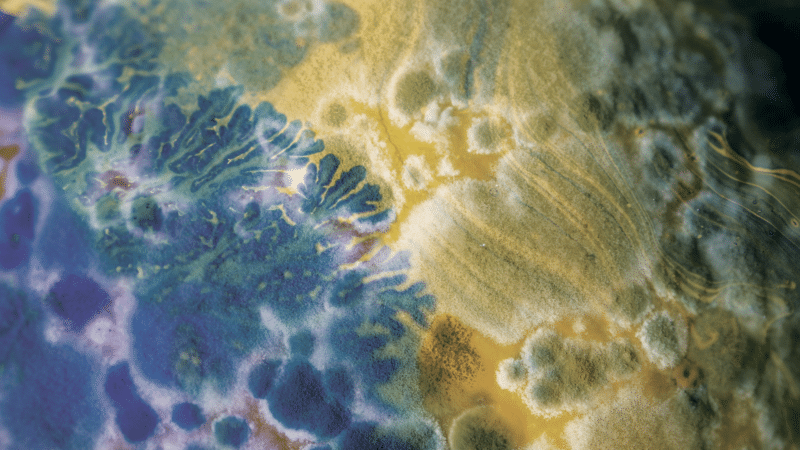
what is biodesign challenge grushkin

A Biodesign Challenge
The Biodesign Challenge (BDC) connects high school and university students with artists, designers, and biologists to critique, create, and envision the future of biotechnology. Students ideate and create designs that address topics in architecture, food, medicine, materials, fashion, and more. Each June, teams showcase their projects at the BDC Summit before a global audience, including 50 interdisciplinary judges who award the coveted Glass Microbe.

April 01, 2022
Could Bacteria and Algae Make a Tree?
VISION: Turn food byproducts into wood alternatives Team: Gabriel Tavas, Angela Andrada, Jared Fligelman, Kanika Leang, Eddie Rajcevic, Hannah Gaffner A single hardwood tree takes decades to grow to the size where… Read More
All Posts in this Collection
-

March 11, 2022
What If Our Phones Had Skin?
VISION: Sheathe cell phones in a living, electricity-generating skin made by bacteria, changing how we relate to them and how they are charged. Team: Nada Elkharashi, Sequoia Fischer, Catherine Euale, Paige Perillat-Piratoine… Read More
-

February 25, 2022
Can Food Scraps Reduce Electronic Waste?
VISION: Replace petroleum-based plastics in electronics with a carbon-capturing bioplastic made from agricultural waste. TEAM: Jessica Smith, Charlotte Böhning, Mary Lempres SCHOOL: Pratt Institute In 2019, the United States generated nearly… Read More
-

February 04, 2022
Can a Sensor-Laden Hoodie Protect Vulnerable Communities?
VISION: Safeguard communities of color against violence through a network-linked fashion line of hoodies. Team: Mika Campbell, Grace Burch, Abigail Gordon, Savannah Adams School: Spelman College When 17-year-old Trayvon Martin was shot… Read More
-

January 21, 2022
Can Satire Change Minds About Invasive Species?
VISION: Drop militaristic rhetoric from ecosystems management to reconsider the national response to invasive species. Team: Dominic Zelli, Jonathan Alexander, Ashlyn Sterling, Erin Mawhorter School: Ball State University When invasive species make… Read More
-

December 17, 2021
Can Crop Waste Reduce Plastic Pollution?
VISION: Use agricultural byproducts like molasses from sugar beets and spent grains from beer to make plastic consumer packaging more sustainable and circular. Team: Joseph Cardenas, Sarah Craven School:… Read More
-

December 03, 2021
Can Fungus Fix Our Plastic Problem?
VISION: Replace single-use plastic packaging with a sustainable, biodegradable alternative made from mushrooms and silkworm cocoons. Team: Sara Selmić, Kelly Xi School: School of the Art Institute of Chicago (SAIC),… Read More
-

November 19, 2021
Can Dirty Playgrounds Build Healthy Communities?
VISION: Encourage community-built public playgrounds that foster microorganism-rich dirt to remediate industrial toxins and provide space for gardening. Team: Manuel Steitz, Coltrane McDowell, Serina Tarkhanian School: Design Academy Eindhoven (2021)… Read More
-

October 29, 2021
Can Tree Bark Make Clothes Better for Us—and the Planet?
VISION: Make fabric more sustainable, antibacterial, and UV-protective using compounds found in the inner bark of spruce trees, a byproduct of Finland’s timber industry. School: Aalto University (2020) One recent… Read More
-
June 17, 2021
What Is Biodesign?
In 2009 Nature Biotechnology asked a group of synthetic biologists to define “synthetic biology.” None of the scientists could agree on a definition. Yet today the synthetic biology market—a field evidently without… Read More
